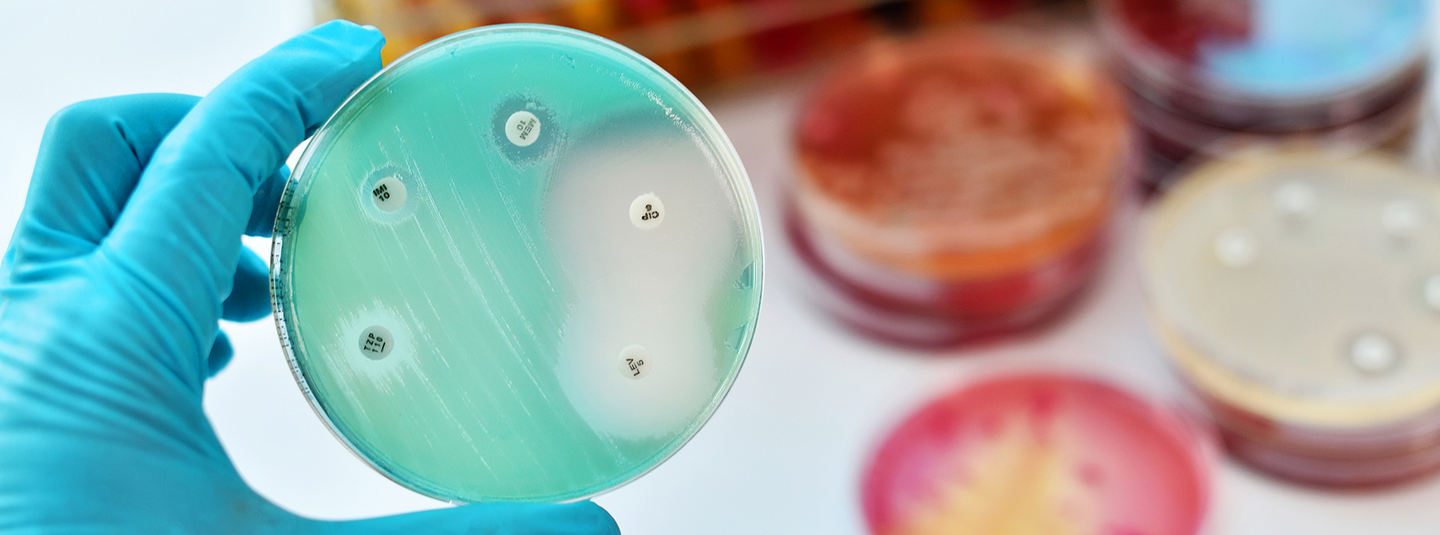

Антимікробна резистентність
Рекомендації ВООЗ
- Global Framework for Development & Stewardship to Combat Antimicrobial Resistance, 2017
- Глобальный план действий по борьбе с устойчивостью к противомикробным препаратам, ВОЗ, 2016
- Antimicrobial Resistance: A Manual for Developing National Action Plans, 2016
- Guidelines on Core Components of Infection Prevention and Control Programmes at the National and Acute Health Care Facility Level, WHO, 2016
- Antibiotic Resistance: Multi-Country Public Awareness Survey, WHO, 2015
Нормативно-правові документи
- Розпорядження КМУ від 6 березня 2019 року № 116-р «Про затвердження Національного плану дій щодо боротьби із стійкістю до протимікробних препаратів»
- Наказ МОЗ від 05.04.2007 № 167 «Про затвердження методичних вказівок „Визначення чутливості мікроорганізмів до антибактеріальних препаратів“»
- Переклад «Європейського плану дій боротьби зі стійкістю до протимікробних препаратів (СПП) «Єдине здоров’я» (від 29.06.2017)
- Переклад «Плану дій з приводу зростання ризику розвитку стійкості до протимікробних препаратів» (від 15.11.2011)
Епідеміологічний нагляд за антимікробною резистентністю
Програми контролю ІПНМД АМР
- Совершенствование профилактики инфекций и инфекционного контроля в учреждениях здравоохранения, WHO, 2018
Система епідеміологічного нагляду за ІПНМД та АМР
- Епідеміологічні і мікробіологічні аспекти боротьби із розповсюдженням інфекцій
- Кількісні методи госпітальної епідеміології
- Принципи епідеміологічного нагляду
Використання антимікробних препаратів
Результати моніторингу